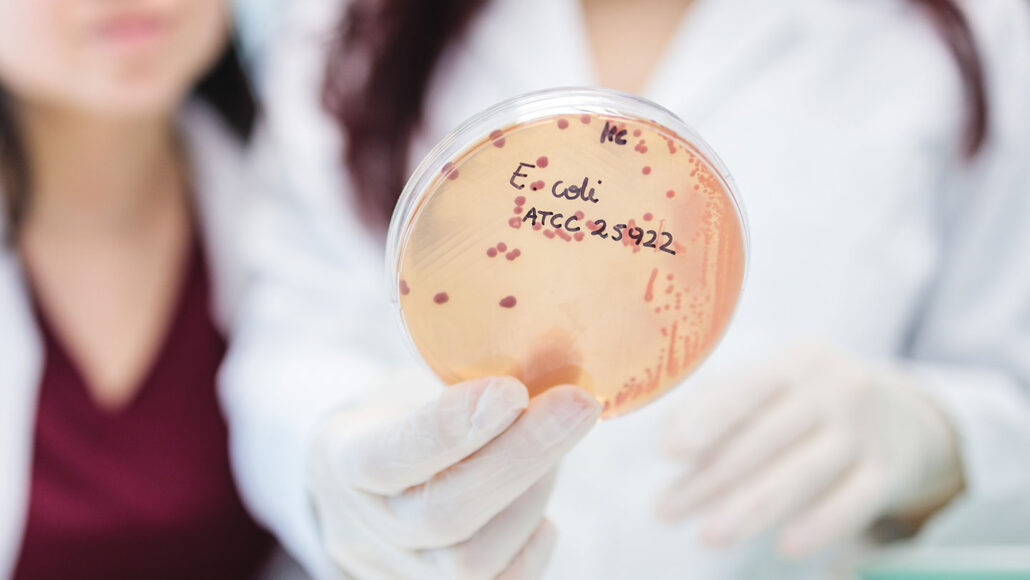
d271a2909811f3a808accbcad4823465.jpg

В Совфеде предложили разработать детский режим SIM-карт Самер Мустафа true true true

Специальный детский режим SIM-карт необходимо разработать и внедрить для защиты детей. Об этом ТАСС рассказал заместитель председателя совета по развитию цифровой экономики при Совете Федерации, сенатор Артем Шейкин.
По его словам, данная мера нужна для защиты детей от мошенников и киберрисков. Сенатор добавил, что сейчас в России действует система белых списков сервисов при временных ограничениях мобильного интернета.
Шейкин считает, что такой опыт можно развить, например, создать специальный детский режим, когда телефон ребенка работает только с проверенными контактами и сайтами. При подозрительных звонках уведомление в таком режиме будет поступать родителям.
Сенатор также отметил, что в настоящее время важно использовать детский режим в телефонах, предусматривающий ограничение на установку приложений, фильтрацию звонков и сообщений.
В октябре сообщалось, что количество несовершеннолетних, пострадавших от киберпреступлений за девять месяцев 2025 года, выросло более чем на 100% к прошлому году.
Ранее в России участились случаи мошенничества с приложениями родительского контроля.